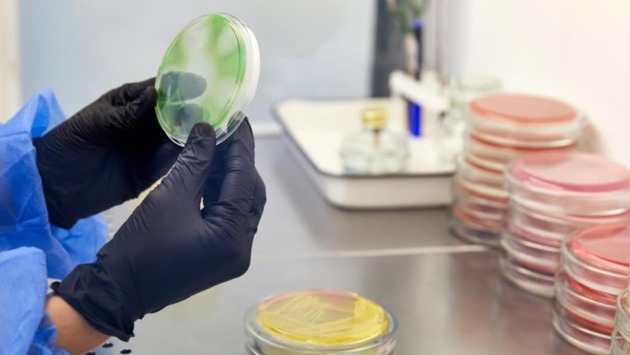

Раздавливаем ли мы микробы, когда наступаем на них
Кожура банана, если на неё наступить, легко остаётся прижатой к земле, а с камнем такого не происходит. Но что насчёт микробов? Сохраняют ли они свою форму, когда мы наступаем на них?
Никто из профессоров из Университета штата Колорадо - Ашока Прасада и Кеннета Ф. Рирдона - в лаборатории ещё не пытался раздавить микробы. Но всё же они могут примерно сказать, что будет, если это произойдёт.
Сила шага человека зависит от его веса. Также важную роль играет площадь, по которой распределяется сила на стопе, создающей давление. Рассчитать показатели давления можно, если разделить вес объекта на его площадь. Допустим, если ваша стопа представляет собой прямоугольник длиной 18 см и шириной 10 см, то площадь её поверхности составит 180 квадратных см. При весе 50 кг сила, которую вы прилагаете на квадратный сантиметр, будет равняться примерно 0,3 кг на квадратный сантиметр.
Бактерии имеют самую разную форму: от сфер до палочек и спиралей. А ещё бактериальные клетки имеют стенки, которые защищают их внутренности от воздействия окружающей среды. Исследования показали, что, например, чтобы раздавить обычной почвенной бактерии Bacillus subtilis потребуется понадобится давление 134 кг на квадратный сантиметр. Это во много раз больше давления, которое ваши кроссовки будут оказывать на тротуар и любые микробы, находящиеся вокруг.
Ещё одна проблема заключается в том, что бактерии очень маленькие. Средняя бактерия имеет размер от 1 до 5 микрон или миллионных долей метра (кончик обычной булавки имеет диаметр примерно 130 микрон). Большинство бактерий, на которые вы наступаете, так и будут раздавлены: они окажутся в бороздах вашей кожи или в особых «канавках» на подошве обуви.
Теоретически для того, чтобы раздавить бактериальную клетку, нужно надеть обувь с заострённой подошвой. Причём диаметр каблука должен быть равен диаметру кончика булавки.